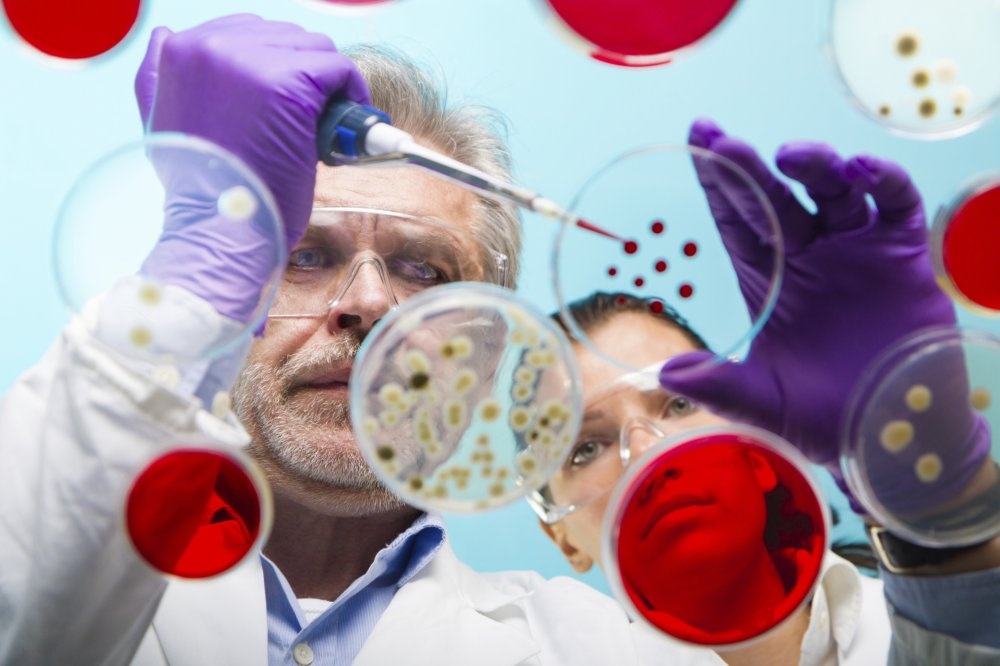
Đến thời điểm nay, VN vẫn

Chiều 20/8, Văn phòng đáp ứng khẩn cấp Cục Y tế dự phòng (Bộ Y tế) đã thông báo tình hình sức khỏe của hai trường hợp hành khách người Nigeria được cách ly tạm thời từ ngày 19/8 tại bênh viện Nhiệt đới TP.HCM.
Cụ thể, TS Trần Đắc Phu, Cục trưởng cục Y tế dự phòng cho biết, hai hành khách sau khi được cách ly từ ngày 19/8 tại bệnh viện Nhiệt đới TP.HCM đã được tiến hành kiểm tra và chăm sóc sức khỏe.
![]() |
| Đến thời điểm nay, VN vẫn "an toàn" với virus Ebola |
Qua 24 giờ theo dõi, hai hành khách không có biểu hiện sốt, không có biểu hiện bất thường cũng như không phát hiện triệu chứng liên quan đến bệnh Ebola.
Căn cứ vào tình hình sức khỏe của hai hành khách, Bộ Y tế đã trao đổi với Tổ chức Y tế thế giới, Trung tâm Kiểm soát và phòng ngừa bệnh tật Hoa Kỳ thống nhất không tiến hành cách ly tại bệnh viện mà thực hiện chuyển sang các biện pháp theo dõi giám sát tại cộng đồng trong vòng 21 ngày tại nơi lưu trú kể từ khi hai trường hợp này xuất phát từ vùng có dịch.
Trao đổi với Zing.vn, Giám đốc Bệnh viện Bệnh Nhiệt đới TP.HCM, Nguyễn Văn Vĩnh Châu cho biết thêm, hai hành khách được phát hiện sốt qua máy đo thân nhiệt từ xa tại sân bay Tân Sơn Nhất chiều 19/8.
Nhưng khi về tới bệnh viện Bệnh Nhiệt Đới, kiểm tra lại thân nhiệt và theo dõi thì không thấy nhiệt độ cơ thể của họ có gì bất thường. Hai hành khách không còn dấu hiệu sốt cũng như không có triệu chứng gì khác. Cả hai đều không phải điều trị thuốc mà chỉ theo dõi sức khỏe.
"Theo lộ trình qua 24 giờ kể từ lúc cách ly, cộng với một vài kết quả xét nghiệm nữa, nếu không có phát hiện triệu chứng gì thêm thì có có lý do gì để giữ họ”, Giám đốc Châu nói.
Vẫn theo TS Châu, hiện ngành y tế và các cơ quan liên quan vẫn giám sát rất chặt những người nhập cảnh. Người dân có thể hoàn toàn yên tâm vì không có bệnh nhân mắc bệnh thì không thể bị lây bệnh.
Như vậy đến thời điểm này Việt Nam vẫn "an toàn" với virus Ebola. Việt Nam vẫn ở tình huống 1, tức chưa phát hiện ca bệnh.
Theo thống kê của cục Y tế dự phòng, hiện thế giới đã ghi nhận 2.127 trường hợp mắc bệnh do virus Ebola, trong số này 1.145 người đã tử vong tại 4 quốc gia Tây Phi gồm: Guinea, Liberia, Nigeria và Sierra Leone.